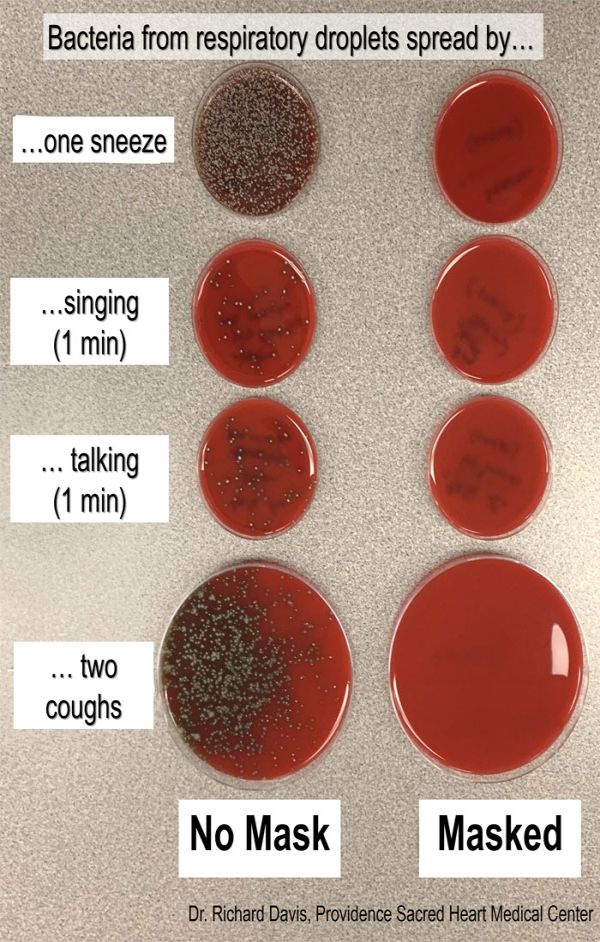
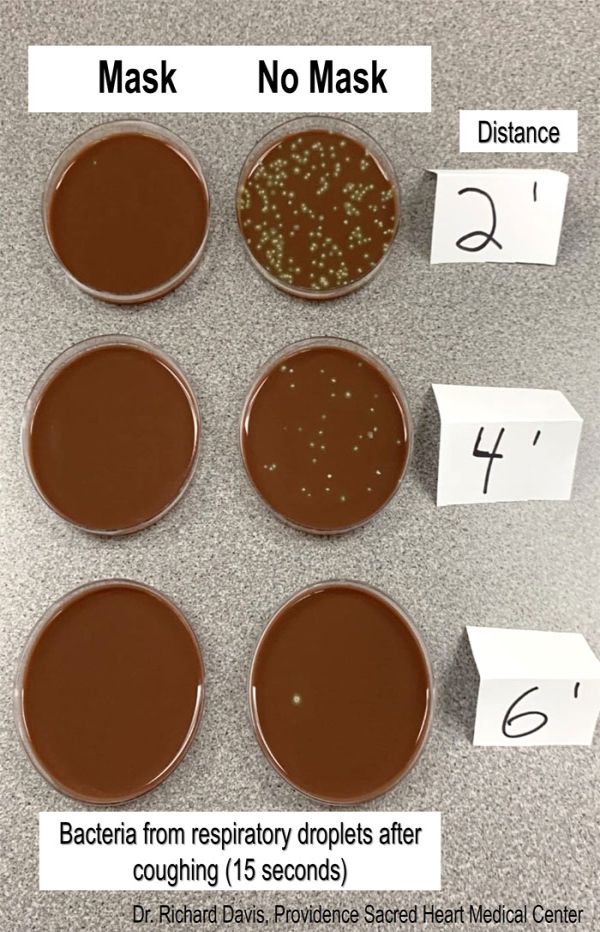

И покрај тоа што многу земји ги релаксираат мерките и бизнисите повторно се отвораат, пандемијата не е помината. Ова значи дека носењето маскa е исто толку важно сега како и пред еден или два месецa. Сепак, на многу места маските само се препорачуваат и не се задолжителни, иако носењето прави голема разлика.
Истражувачот Рич Дејвис на „Твитер“ објави пост во кој покажува колку е важно да се носи маска преку едноставен експеримент со употреба на култури на агар. Научникот покажа дека маските во голема мера го намалуваат ширењето на респираторните капки и бактерии, што е вистинска победа кога сме среде пандемија.
- Што прави маската? Ги блокира респираторните капки што доаѓаат од вашата уста и грло.
Прво кивнав, пеев, зборував и се искашлав кон културите на агар со и без маска. Колониите на бактериите покажуваат каде застанале капките. Маската ги блокира сите.
Фото: Rich Davis
Втората демонстрација научникот ја посветил на социјалното дистанцирање.
- Ги оставив отворени културите на бактерии и бев оддалечен 0,6 метри, 1 метар и 2 метра и се искашлав во период од 15 секунди. Ова го направив и без маска.
Фото: Rich Davis
Како што се може да се види од колониите на бактерии, капките главно застанаа кога бев оддалечен помалку од 2 метра, но
маската ги блокира речиси сите.
Фото: Twitter